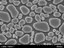

16122018.jpg
16122018.jpg
2018
16122018.jpg
16122018.jpg
 Новый способ синтеза тонких ферромагнитных пленок для микросхем
Новый способ синтеза тонких ферромагнитных пленок для микросхем
Ученые Института физики им. Л. В. Киренского ФИЦ КНЦ СО РАН совместно с коллегами научились синтезировать тонкие кристаллические ферромагнитные пленки и разработали технологию придания им нужной формы. Такие пластины могут использоваться в электронных и спинтронных микросхемах.
 Композиционный материал из графена и дисульфида ванадия повысит емкость и скорость заряда литий-ионных батарей
Композиционный материал из графена и дисульфида ванадия повысит емкость и скорость заряда литий-ионных батарей
Ученые из Института физики им. Л.В. Киренского ФИЦ КНЦ СО РАН совместно с коллегами из СФУ и Национального исследовательского технологического университета «МИСиС» предложили использовать соединение графена с монослоем дисульфидом ванадия в качестве анодного материала для литий-ионных батарей. Благодаря этому повысятся емкость, максимальная скорость заряда-разряда элементов питания.
 Учёные Института физики СО РАН (ФИЦ КНЦ СО РАН) нашли способ усовершенствовать магнитные датчики
Учёные Института физики СО РАН (ФИЦ КНЦ СО РАН) нашли способ усовершенствовать магнитные датчики
Обнаружили высокую чувствительность электронов к магнитному полю при их перемещении в гибридных структурах, состоящих из ферромагнетика, полупроводника и оксида. Благодаря этому свойству можно построить электронные устройства, управляемые магнитным полем, а также расширить возможности существующих магнитных датчиков.
 Дилатометр измерит деформации космических материалов в вакууме
Дилатометр измерит деформации космических материалов в вакууме
12.04.2018
 Красноярские ученые рассказали зачем зондировать почву в Арктике
Красноярские ученые рассказали зачем зондировать почву в Арктике
28.03.2018
05.04.2018. Три проекта ученых Федерального исследовательского центра Красноярский научный центр СО РАН стали победителями ежегодного конкурса грантов Российского научного фонда по приоритетному направлению «Проведение фундаментальных научных исследований и поисковых научных исследований отдельными научными группами». Проект-победитель: «Влияние обменного взаимодействия между возбужденными состояниями на спиновые кроссоверы в равновесных и неравновесных условиях», Институт физики им. Л.В. Киренского ФИЦ КНЦ СО РАН. Руководитель проекта - д.ф.м.н., профессор Овчинников С.Г.
 Как поймать свет
Как поймать свет
Интервью с д.ф.м.н., профессором Садреевым Алмазом Фаттаховичем
 Не принимаю предложения работать за границей
Не принимаю предложения работать за границей
Интервью с к.ф.м.н. Молокеевым Максимом Сергеевичем
Сотрудники Института физики Максим Сергеевич Молокеев и Максим Михайлович Коршунов получили награду «Top 1% in Field» в рамках премии Peer Review Awards 2018.
Комментирует доктор физико-математических наук, старший научный сотрудник Института физики им. Л.В. Киренского СО РАН Иван Тимофеев
Операции с документом
